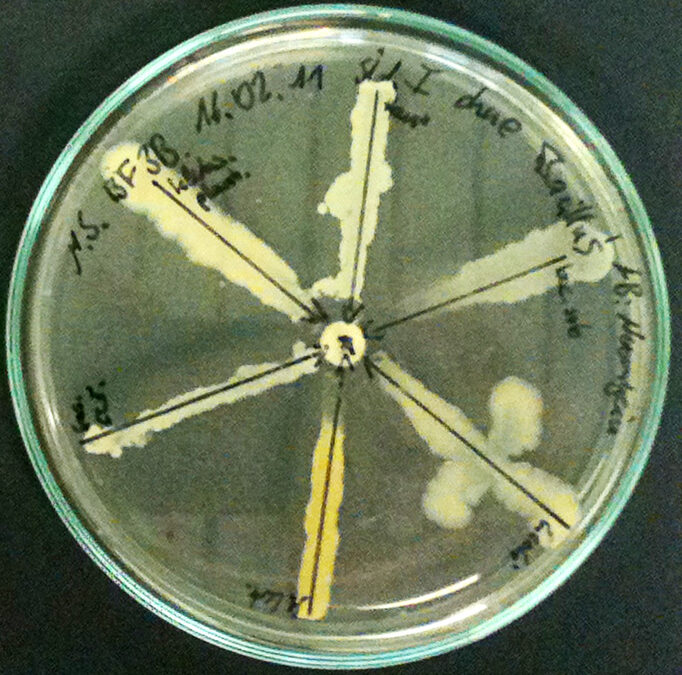

Di Sara Moraca
Un nuovo studio pubblicato su The Lancet prevede che oltre 39 milioni di persone potrebbero morire a causa di infezioni resistenti agli antibiotici entro il 2050. Questa ricerca, condotta dal Global Research on Antimicrobial Resistance (GRAM) Project, rappresenta la prima analisi globale approfondita dei trend di resistenza antimicrobica (AMR) tra il 1990 e il 2021 e delle loro proiezioni fino alla metà del secolo. Lo studio ha esaminato 204 paesi e territori, tracciando un quadro preoccupante per il futuro della salute globale.
L’impatto globale dell’antibiotico-resistenza
Secondo lo studio, tra il 1990 e il 2021, oltre un milione di persone è morto ogni anno a causa di infezioni legate all’AMR. Questo numero, però, è destinato ad aumentare drammaticamente nei prossimi decenni. I ricercatori stimano che entro il 2050 i decessi causati direttamente da infezioni resistenti agli antibiotici potrebbero aumentare del 70%, passando da 1,14 milioni nel 2021 a 1,91 milioni. Allo stesso tempo, il numero di morti in cui i batteri resistenti svolgono un ruolo indiretto potrebbe aumentare del 75%, passando da 4,71 milioni di decessi all’anno a 8,22 milioni.
Uno degli aspetti più rilevanti di questa analisi è il cambiamento nella distribuzione delle morti per fasce di età. Tra il 1990 e il 2021, i decessi causati da AMR tra i bambini sotto i cinque anni sono diminuiti del 50%, grazie a miglioramenti significativi nella prevenzione e nel controllo delle infezioni infantili, come i programmi di vaccinazione. Tuttavia, nello stesso periodo, le morti tra le persone anziane, di età superiore ai 70 anni, sono aumentate dell’80%. Questa tendenza è destinata a proseguire: entro il 2050, il numero di morti tra i bambini sotto i cinque anni continuerà a diminuire, dimezzandosi ulteriormente, mentre i decessi tra gli anziani raddoppieranno.
L’antibiotico-resistenza: una crisi sanitaria globale
L’antibiotico-resistenza è considerata una delle principali minacce alla salute pubblica globale. Quando i batteri o altri patogeni diventano resistenti agli antimicrobici, trattare infezioni comuni diventa sempre più difficile, se non impossibile. Questa resistenza si sviluppa quando i microrganismi si evolvono in modo tale da non rispondere più ai farmaci destinati a eliminarli, rendendo inefficaci cure che una volta funzionavano.
Secondo il prof. Mohsen Naghavi, responsabile del team di ricerca AMR presso l’Institute of Health Metrics and Evaluation (IHME) dell’Università di Washington, USA, “i medicinali antimicrobici sono una delle colonne portanti dell’assistenza sanitaria moderna, e l’aumento della resistenza ad essi è una causa di grande preoccupazione. Questi risultati evidenziano che l’AMR rappresenta una minaccia significativa per la salute globale da decenni e che questa minaccia è in crescita”.
Nonostante la crescente consapevolezza della gravità dell’antibiotico-resistenza, fino a questo momento non esisteva un’analisi dettagliata che esaminasse i trend storici dell’AMR e fornisse previsioni sul futuro impatto globale. Il primo studio GRAM, pubblicato nel 2022, aveva già rivelato l’enorme scala del problema, dimostrando che i decessi globali associati all’AMR nel 2019 superavano quelli causati dall’HIV/AIDS e dalla malaria, portando direttamente a 1,2 milioni di decessi e contribuendo a ulteriori 4,95 milioni.
Dati chiave e proiezioni future
Lo studio GRAM ha esaminato 22 patogeni, 84 combinazioni patogeno-farmaco e 11 sindromi infettive (inclusi meningite e infezioni del sangue) tra persone di tutte le età in 204 paesi e territori. Le stime sono state prodotte utilizzando modelli statistici basati su oltre 520 milioni di record individuali, inclusi dati ospedalieri, certificati di morte e informazioni sull’uso di antibiotici. Questo approccio ha consentito di produrre previsioni dettagliate sull’evoluzione dell’AMR, non solo a livello globale, ma anche regionale.
Secondo queste proiezioni, le infezioni resistenti agli antibiotici causeranno il maggior numero di decessi in Asia meridionale, una regione che include paesi come India, Pakistan e Bangladesh, dove si prevede che tra il 2025 e il 2050 l’AMR sarà responsabile di 11,8 milioni di morti. Anche altre regioni del sud-est asiatico, dell’Asia orientale e dell’Africa sub-sahariana subiranno un impatto significativo.
Le regioni in cui si è registrato il maggior aumento di decessi causati direttamente dall’AMR tra il 1990 e il 2021 includono l’Africa sub-sahariana occidentale, l’America Latina tropicale, il Nord America ad alto reddito, il sud-est asiatico e il sud dell’Asia. In queste aree, il numero di decessi annuali è aumentato di oltre 10.000 unità nel periodo analizzato.
In particolare, le infezioni da Staphylococcus aureus resistente alla meticillina (MRSA) sono quelle che hanno causato il maggior aumento dei decessi a livello globale. Nel 2021, queste infezioni sono state responsabili di 130.000 decessi, più del doppio rispetto ai 57.200 del 1990. Tra i batteri Gram-negativi, noti per la loro elevata resistenza, l’aumento più preoccupante è stato quello della resistenza ai carbapenemi, con 216.000 morti nel 2021 rispetto ai 127.000 del 1990.
Interventi urgenti per prevenire una crisi sanitaria
Secondo gli autori dello studio, è ancora possibile invertire questa tendenza, ma è necessaria un’azione urgente. Le proiezioni indicano che migliorare l’accesso alle cure sanitarie e agli antibiotici potrebbe salvare fino a 92 milioni di vite tra il 2025 e il 2050. Gli interventi più efficaci riguarderebbero l’Asia meridionale, l’Africa sub-sahariana e il sud-est asiatico, dove si potrebbero evitare rispettivamente 31,7 milioni, 25,2 milioni e 18,7 milioni di decessi.
Un altro scenario che potrebbe salvare milioni di vite prevede lo sviluppo di nuovi antibiotici specifici per i batteri Gram-negativi. Secondo le stime, questo tipo di innovazione potrebbe prevenire 11,08 milioni di decessi a livello globale nello stesso periodo.
“Abbiamo fatto progressi significativi nel contrastare l’antibiotico-resistenza, soprattutto tra i bambini, ma i nostri risultati indicano che è necessario fare molto di più per proteggere la popolazione mondiale da questa minaccia crescente”, ha affermato il prof Stein Emil Vollset dell’Istituto norvegese di sanità pubblica e professore affiliato all’IHME. “Per prevenire un disastro sanitario globale, è essenziale implementare nuove strategie, come lo sviluppo di vaccini, nuovi farmaci e una gestione più efficace degli antibiotici esistenti”.
- GBD 2021 Antimicrobial Resistance Collaborators. Global burden of bacterial antimicrobial resistance 1990-2021: a systematic analysis with forecasts to 2050 Lancet. 2024 Sep 28;404(10459):1199-1226. DOI: 10.1016/S0140-6736(24)01867-1